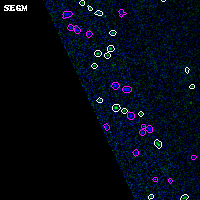

ABELL697 ACS+IR detection object #1516
Color images and BPZ results
Catalog: 1516.cat
Black segments are analyzed here. Roll mouse over color images to view segments.
Best viewed in a wide browser window (1200 pixels or more). Download SED & P(z) plots to view larger versions.
In P(z) plots: Yellow lines mark the cluster redshift z = 0.282,
Object #1516 x,y = (404, 2792) RA, Dec = (08:43:09.648, 36:22:09.12) = (130.79020, 36.36920) BPZ = 0.730 [0.246--5.212] type = 3.00 (Ell5_A_0) chisq2 = 0.03 ODDS = 0.10 z_cluster = 0.282